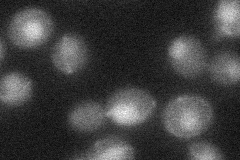
YPL024W
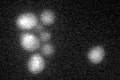
YPL024W
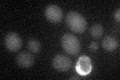
YPL024W

View description
Subunit of the RecQ (Sgs1p) - Topo III (Top3p) complex; stimulates superhelical relaxing and ssDNA binding activities of Top3p; involved in response to DNA damage; null mutants display increased rates of recombination and delayed S phase
Localization:
Intensity:
Fold change:
Significance:
-
C’ GFP library in SD

nucleus20.57 -
N' NOP1pr-GFP in SD

nucleus66.8294 -
N' TEF2pr-mCherry in SD

nucleus51.8615 -
N' NATIVEpr-GFP in SD

punctate,nucleus23.6123 -
N' TEF2pr-VC and Cyto-VN in SD
nucleus29.6439 -
C’ GFP library in SD+DTT
nucleus20.450.99No -
C’ GFP library in SD+H2O2

nucleus16.920.82Yes -
C’ GFP library in Starvation Media
nucleus23.721.15No -
C’ GFP library on the background of Pup2-DaMP

nucleus -
C’ GFP library on the background of CCT mutant

nucleus21.88141.06303No
